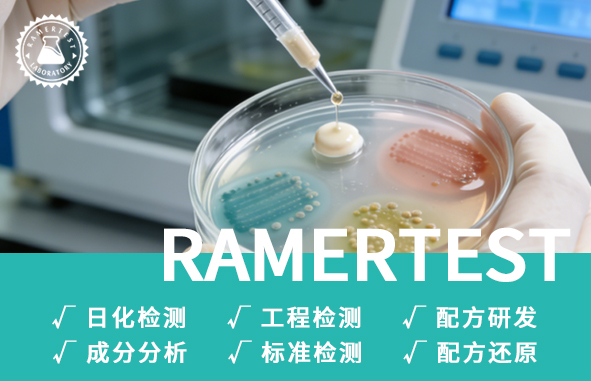

拉姆化妆品联合实验室——化妆品里的“隐形刺客”?微生物检测告诉你真相!Ram Cosmetics J...
2026-02-03
拉姆化妆品联合实验室——PDRN:开启肌肤“自我修复力”的生物科技钥匙Ram Cosmetics J...
2026-01-28
拉姆化妆品联合实验室——聚氯乙烯(PVC)全成分检测解析及行业应用指南Ram Cosmetics J...
2026-01-20
拉姆化妆品联合实验室——别被“高浓度蛇毒肽”忽悠!含量够才有效,这份检测指南帮你避坑Ram Cosm...
2026-01-14
拉姆化妆品联合实验室——如何精准检测溴代三嗪阻燃剂?Ram Cosmetics Joint Labo...
2026-01-06
拉姆化妆品联合实验室——微生物检测如何守护你的美丽安全?Ram Cosmetics Joint La...
2025-12-30
拉姆化妆品联合实验室——重塑年轻:解码化妆品中的“重组胶原蛋白”Ram Cosmetics Join...
2025-12-23
拉姆化妆品联合实验室——塑料助剂:小助剂大作用,检测护航更安心Ram Cosmetics Joint...
2025-12-18
在化妆品行业合规监管日益严格的背景下,糖皮质激素类物质作为明确的禁用成分,始终是监管排查与企业风险防...
2025-12-10
拉姆化妆品联合实验室——揭秘DOPO阻燃剂化学检测:实验室里的分子密码破译Ram Cosmetics...
2025-12-02
拉姆化妆品联合实验室——守护美的代价:你所不知道的,化妆品安全背后的“军备竞赛”Ram Cosmet...
2025-11-25
拉姆化妆品联合实验室——类蛇毒肽:源自致命毒液的驻颜奇迹Ram Cosmetics Joint La...
2025-11-19
拉姆化妆品联合实验室——无处不在的聚酯:从衣物到饮料瓶的 “身份” 之旅Ram Cosmetics ...
2025-11-13
拉姆化妆品联合实验室——800 余款化妆品检出苏丹红!涉事品牌及自查、检测指南Ram Cosmeti...
2025-11-05
拉姆化妆品联合实验室——实验室质量管控:多聚甲醛达标检测全攻略,这些指标一个都不能少!Ram Cos...
2025-10-29
拉姆化妆品联合实验室——专业实验室为您筑牢产品安全防线Ram Cosmetics Joint Lab...
2025-10-21
拉姆化妆品联合实验室——嘿,你的皮肤在呼叫‘377’!这份白到发光的攻略请收好!Ram Cosmet...
2025-10-14
拉姆化妆品联合实验室——你用的化妆品,可能藏着“看不见的杀手”?微生物检测才是安全底线Ram Cos...
2025-09-30
拉姆化妆品联合实验室——熊果苷:肌肤的“调光师”,美白界的科学优等生Ram Cosmetics Jo...
2025-09-23
拉姆化妆品联合实验室——塑料之王变身记:聚四氟乙烯改性配方与性能大揭秘Ram Cosmetics J...
2025-09-11公司简介
© 2023 拉姆技研科技开发(上海)有限公司 all rights reserved